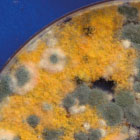

Gutachten
In allen Berufen – so auch bei den Architekten – braucht man Leute, die in der Lage sind, komplexe Sachverhalte ihres Fachgebiets zu beurteilen und darüber Berichte oder Gutachten zu erstellen – sogenannte Sachverständige. Sie können im Vorfeld von Projekten beratend, bei der Realisierung begleitend und später begutachtend tätig sein – eine hoch angesehene und auch kreative Tätigkeit. Sie verlangt neben ausreichender Berufserfahrung besondere Sachkunde auf dem gewählten Fachgebiet und die Fähigkeit, sich auch bei komplizierten Sachverhalten für Laien verständlich auszudrücken.
Mit der Fachliste "Sachverständigenwesen" in der Herr Schwöbel eingetragen ist stellt die Architektenkammer Baden-Württemberg eine Liste besonders qualifizierter Architektinnen und Architekten für diesen spezifischen Leistungsbereich zur Verfügung. Mit den Fachlisten wird das Ziel verfolgt, private, gewerbliche und öffentliche Bauherren sowie Kommunen, Behörden, Investoren und sonstige Vorhabensträger bei der Suche und Auswahl geeigneter Experten zu unterstützen. Die Mitglieder dieser Fachliste haben entsprechend eine besondere Qualifikation nachgewiesen und sind daher prädestiniert, die Leistungen als Sachverständige für die Sachgebiete "Bewertung von unbebauten und bebauten Grundstücken", "Schäden an Gebäuden", "Schäden an Freianlagen" und "Architektenhonorare" zu erbringen.